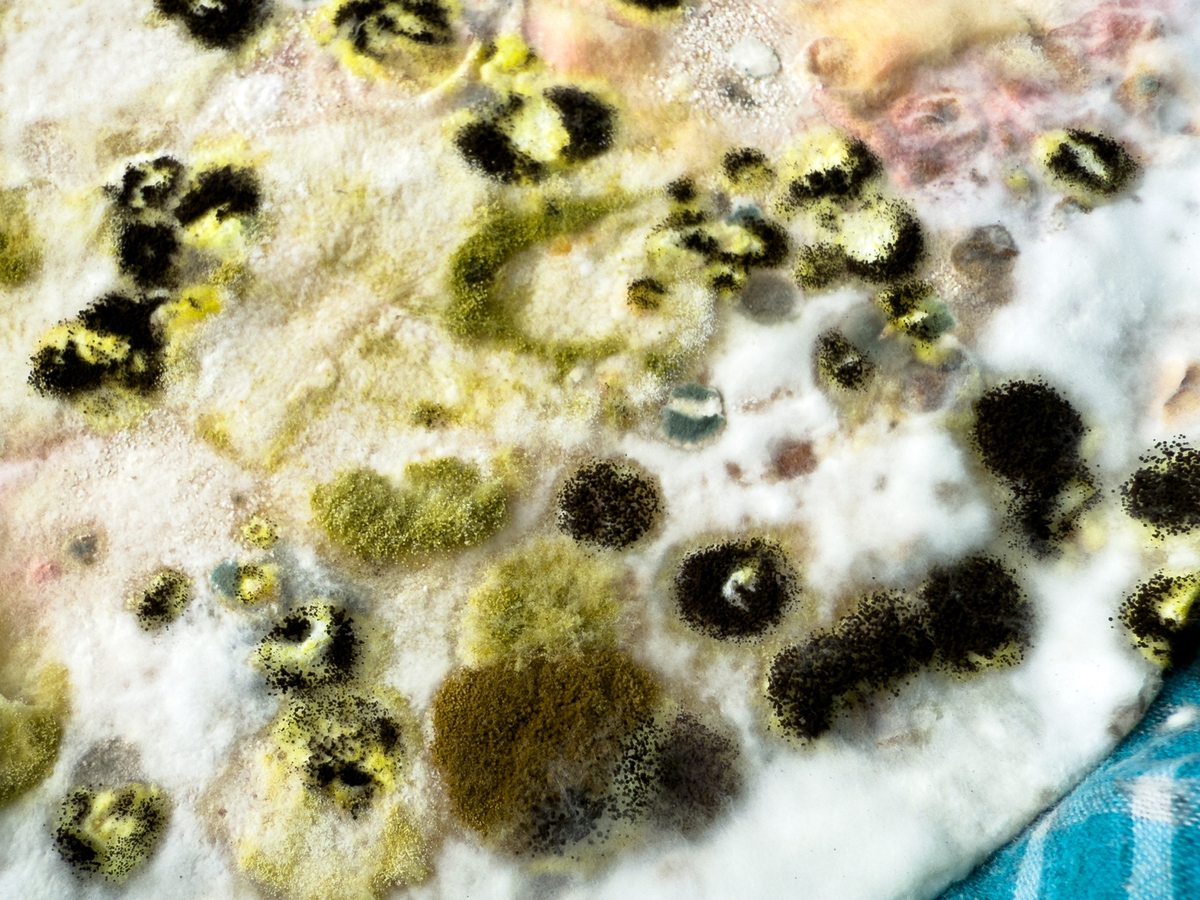
粮食发霉怎么办？教你正确处理方法！

粮食发霉怎么办?教你正确处理方法!
你的粮食发霉了?不要慌张!我们来告诉你如何处理。第一步,不要食用发霉的粮食,因为霉菌产生的毒素可能对身体健康造成伤害。第二步,将发霉的粮食远离其他食物,以防止霉菌传播。第三步,彻底清洁和消毒储存粮食的容器,以防止霉菌再次滋生。第四步,购买透明的储存容器,以便更好地观察粮食的状态。最后,定期检查和更换粮食,避免存放过久引发发霉问题。记住,健康的粮食才能为我们提供足够的营养,保持身体的健康。
原文地址: https://www.cveoy.top/t/topic/pTPS 著作权归作者所有。请勿转载和采集!